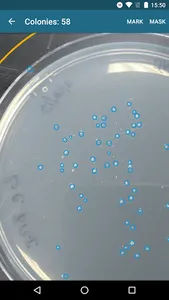

Is the tedium of squinting over agar plates counting bacterial colonies getting to you? Take the plates out of the lab! No, not literally. Snap a picture with your phone and you can make counting an out-of-lab experience. The Colony Counter app gives you a count estimate you can then manually refine. Save single plates or sets for later comparison. Happy Counting!
The fine print: Our app was tested with JM109 High Efficiency Competent Cells grown up in 50ml LB Medium; other plate and colony combos weren’t tested.
The fine print: Our app was tested with JM109 High Efficiency Competent Cells grown up in 50ml LB Medium; other plate and colony combos weren’t tested.
Show More